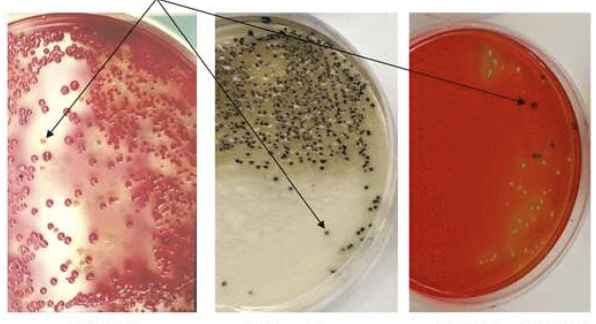
term image

Diagram Review
0.0(0)
Studied by 2 peopleCard Sorting
1/59
Earn XP
Description and Tags
Last updated 4:57 PM on 12/9/22
Name | Mastery | Learn | Test | Matching | Spaced | Call with Kai |
|---|
No analytics yet
Send a link to your students to track their progress
60 Terms
1
New cards

Organic Acids only effective at low pH
2
New cards

The effects of time and temperature on bacteria
3
New cards

Effect of time and temperature on Food safety
4
New cards

Relative growth rates of bacteria at different temperatures
5
New cards

All stages of growth curve are affected by time & temperature
6
New cards

Hurdle theory and Interactions of Inhibitors
7
New cards

Logarithmic thermal death kinetics
8
New cards

Bacterial Survival curve
9
New cards

Z-value
10
New cards

Effect of pH on the decimal reduction time (DRT_ of Enterococcus Faecalis
11
New cards

Comparison of conventional (top) and aseptic (bottom) processing of food
12
New cards

Swollen C. botulinum spores
13
New cards

Spore biology
14
New cards

Spore peptidoglycan - pyridine-2,6-dicarboxylic acid (DPA)
15
New cards

Spiral Platter Method
16
New cards

Membrane Filter
17
New cards
Epifluorescent Technique, Direct Epifluorescence Microscopy
18
New cards

Redox Potential Test
19
New cards

Reductase Test
20
New cards

Swab Test Method
21
New cards

Sponge Method
22
New cards

Simplate System
23
New cards

Monoclonal Antibodies
24
New cards

Latex Agglutination Test
25
New cards

Immuno-magnetic seperation
26
New cards

Salmonella 1-2 Test
27
New cards

BAX system
28
New cards

Real-time PCR
29
New cards

Reverse Transcriptase PCR
30
New cards

RiboPrinter system
31
New cards

Bioluminescence
32
New cards

Total Coliform Fecal Coliform and E.coli / Indicator Organisms
33
New cards

E.Coli )157:H7 Viability on Copper Alloys and Stainless Steel at Room temperature
34
New cards

Decision Tree to choose appropriate sampling plan for a specific application
35
New cards

Salmonella Oxidase test
36
New cards
E.coli Colonies on TC-SMAC, Rainbow agar and R&F E.coli
37
New cards

Number of cases of EHEC strains from 2005 - 2009
38
New cards

Potential Routes of Transmission of L. Monocytogenes
39
New cards

Virulence Factors and Mechanisms of Pathogenicity
40
New cards

Reported Cases of Foodborne Botulism USA, 1992-2012
41
New cards

Age distribution of infant botulism
42
New cards

Wound Botulism
43
New cards

Scanning electron micrograph of C. Botulinum vegetative cells (rods) and spores (irregular Ovals)
44
New cards
Grouping and Characteristics of strains of c. Botulinum
45
New cards

Botulinum toxin structure
46
New cards

Structures of A. flavus (A&B) and A. parasiticus (C&D)
47
New cards

A. P. galbrum
B. P. expansum
C. citrinum
D. P. variabile
B. P. expansum
C. citrinum
D. P. variabile
48
New cards

Fusarium species
A. F. graminearum
B. F. moniliforme
C. F. equiseti
D. F. culmorum
A. F. graminearum
B. F. moniliforme
C. F. equiseti
D. F. culmorum
49
New cards

Aflotoxin B1
50
New cards

Penicillium Species
51
New cards

Bacteriophage
52
New cards

Norovirus
53
New cards

HAV
54
New cards

Prions, left is normal (PRPC) and right is infectious (PRPSC)
55
New cards

Organic Acids
56
New cards

Lysozyme on gram negative and gram positive cells
57
New cards

Class I, Class II Bacteriocins and bacteriolysins
58
New cards

Logarithmic thermal death kinetics
59
New cards

Components of GMP
60
New cards

Flow diagram and CCPs for a non-thermally processed product